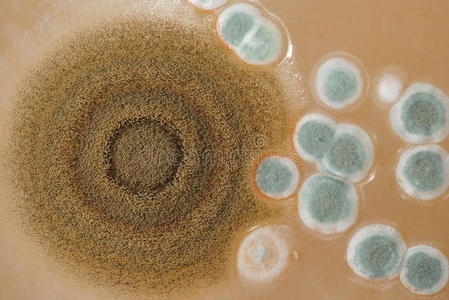
霉菌在琼脂平板上生长的大型霉菌菌落.照片

霉菌菌落图片

霉菌分类之菌落观察——超清的菌落照片(答案在p7)
图片尺寸950x605
从室内空气中培养的霉菌菌落
图片尺寸1100x1100
霉菌菌落
图片尺寸1180x1100
从室内空气中培养的霉菌菌落
图片尺寸1200x800
关于孟加拉红培养基上的菌落,这都是霉菌吗
图片尺寸3120x4160
显微镜下霉菌菌落特征的背景研究.
图片尺寸1200x800
怎么根据菌落形态分辨出是什么菌?
图片尺寸1280x960
化验室 菌落 霉菌 平板 湿度
图片尺寸1444x1221
室内空气中生长着不同的霉菌菌落
图片尺寸1200x800
面包上有霉菌菌落
图片尺寸1200x795
霉菌在琼脂平板上生长的大型霉菌菌落.照片
图片尺寸449x300
真菌菌落室内空气培养的霉菌菌落照片
图片尺寸450x300
常见霉菌形态描述及典型菌落图片汇总_曲霉_菌丝_暗绿色
图片尺寸662x666
霉菌美丽,菌落特性的培养培养基板从实验室微生物.
图片尺寸1200x800
霉菌美丽,菌落特性的培养培养基板从实验室微生物.
图片尺寸1200x800
面包上有霉菌菌落
图片尺寸1200x795
霉菌美丽,菌落特性的培养培养基板从实验室微生物.
图片尺寸1200x800
霉菌美丽,菌落特性的培养培养基板从实验室微生物.
图片尺寸1200x800
"出轨"烟曲霉菌落 胡龙华
图片尺寸600x800
霉菌美丽,菌落特性的培养培养基板从实验室微生物.
图片尺寸1200x800